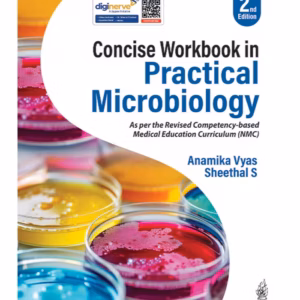

Product categories
- Advance Nursing (5)
- Agadtantra (1)
- Allergy (2)
- Allied Health (16)
- Anatomy (156)
- Anesthesia (67)
- Animal Care (1)
- Audiology (2)
- Ayurved (2)
- Basic Science (5)
- Behavior (1)
- Biochemistry (63)
- Biology (1)
- Biomechanics (1)
- Biophysics (3)
- Biostatistics (1)
- Cardiology (98)
- Chemistry (4)
- Child Health Nursing (3)
- Clinical (4)
- Clinical Pathology (1)
- Communication (11)
- Community Medicine (24)
- Community Nursing (26)
- Computer (4)
- Contact Lens (2)
- Critical Care (40)
- Dental (58)
- Dentistry (71)
- Dermatology (131)
- Dictionaries (1)
- Dictionary (5)
- Disaster Management (2)
- Dravyaguna Vighyan (3)
- Education (2)
- Electrocardiography (4)
- Electrotherapy (6)
- Embryology (8)
- Emergency Medicine (22)
- Endocrinology (36)
- English (5)
- ENT (4)
- Epidemiology (2)
- Exam Preparatory (6)
- Family Medicine (4)
- Financial Management (1)
- Forensic Medicine (19)
- Forensic Nursing (2)
- Gastroenterology (7)
- Gastroenterology & Hepatology (17)
- General (28)
- General Medicine (6)
- Genetics (5)
- Gynaecology (10)
- Health Economics (1)
- Health Management (2)
- Healthcare (2)
- Hematology (18)
- Hepatology (1)
- Histology (8)
- Histopathology (1)
- Hospital Infection (2)
- Hospital Management (2)
- Hospital Planning (4)
- Imaging Technology (9)
- Immunology (4)
- Instruments (2)
- Internal Medicine (121)
- Internship (2)
- Kinesiology (2)
- Laparoscopy (1)
- Manual (4)
- Medical (324)
- Medical Research (4)
- Medicine (135)
- Microbiology (48)
- Midwifery Nursing (19)
- Msn (4)
- Multi Subject (86)
- Neonatology (4)
- Nephrology (11)
- Neurology (82)
- Neurosurgery (63)
- Nursing (322)
- Nutrition (20)
- Obstetric & Gynecology (3)
- Obstetrics & Gynecology (274)
- Occupational Therapy (5)
- Oncology (17)
- Operation Theatre (3)
- Ophthalmology (145)
- Optics (6)
- Oral (14)
- Oral Hygiene (1)
- Oral Surgery (2)
- Orthodontics (7)
- Orthopaedic Surgery (12)
- Orthopaedics (39)
- Orthopaedics Surgery (18)
- Orthopedics (83)
- Osteopathy (1)
- other (1)
- Others (2)
- Otolaryngology (43)
- Pain Management (2)
- Panchkarma (1)
- Parasitology (1)
- Pathology (119)
- Patient Care (1)
- Pediatrics (192)
- Pedodontics (5)
- Periodontics (5)
- Pharmaceutics (2)
- Pharmacology (60)
- Pharmacovigilance (1)
- Pharmacy (5)
- Physical Therapy (27)
- Physiology (61)
- Physiotherapy (19)
- Plastic Surgery (25)
- Prosthodontics (15)
- Psychiatry (39)
- Psychology (21)
- Pulmonary (5)
- Radiology (161)
- Radiotherapy (1)
- Rasashatra (1)
- Record Book (49)
- Rehabilitation (7)
- Rheumatology (7)
- Sanskrit (1)
- Sociology (15)
- Surgery (204)
- Therapeutics (6)
- Ultrasound (2)
- Uncategorized (5)
- Urology (13)
- Vascular Sciences (4)
- Veterinary (44)
- Ward Management (1)
- Waste Management (2)
- Yoga (1)